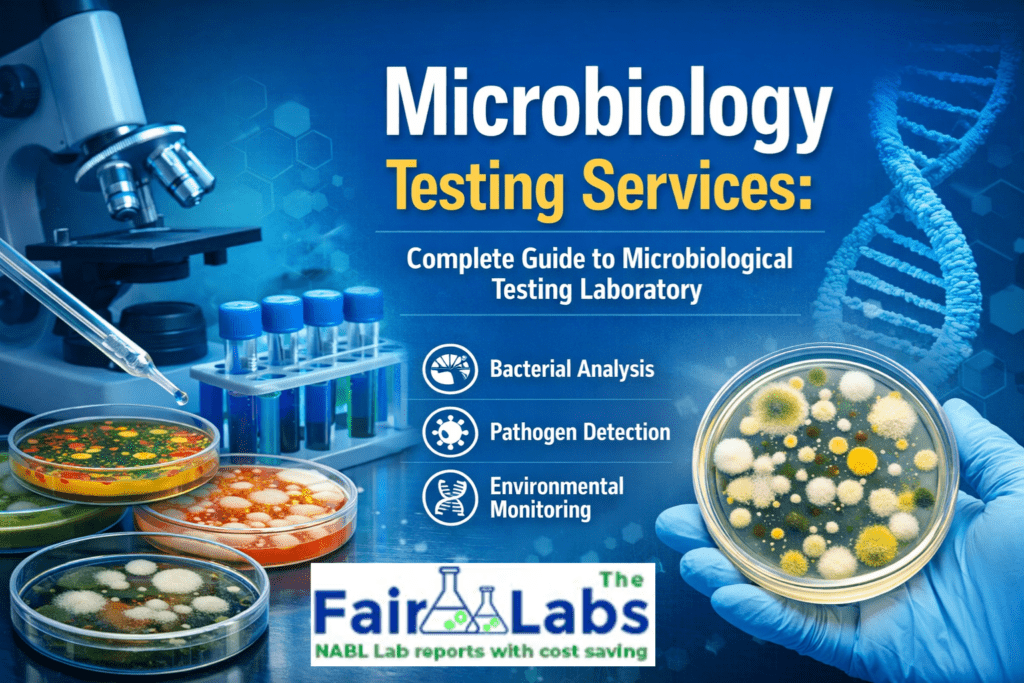
Microbiology Testing Services

In the rapidly changing environment of the industrial world, microbiology testing services have become an integral part of ensuring the safety, quality, and regulatory compliance of products in various industries. For the pharmaceutical, food, cosmetics, or environmental industries, the significance of the role played by the Microbiological Testing Laboratory cannot be emphasized enough. For businesses that aim to deliver quality products to end users, the decision to partner with reliable microbiology testing labs is one that cannot be ignored.
The Fair Lab is at the vanguard of offering the best in microbiology testing solutions, ensuring that the testing services offered are of the highest standard, backed by accreditations from around the world. As a business that requires microbiological testing services and as a researcher that requires the most sophisticated testing for pathogens, understanding the full significance of the role played by microbiology testing is the first step towards making the right decision.
In this complete guide, every aspect of microbiological testing is covered, including the types of testing services offered, the significance of accreditations, the requirements of each industry, the latest in rapid detection, and more, ensuring that you understand the significance of the role played by the best microbiology testing labs.
What is a microbiological testing laboratory?
A microbiological testing laboratory is a scientific research facility with the capability to detect, identify, quantify, and analyze microorganisms such as bacteria, fungi, viruses, and parasites in a wide range of sample types. These laboratories are the building blocks for quality control, research and development, and regulatory and public health protection.
A microbiology services laboratory offers a broad scope of analytical services, specifically designed to meet the needs of diverse industries. The services include sterility tests, microbial limits tests, environmental monitoring, potency tests, and contaminant investigation, all of which are performed using validated techniques in a controlled environment.
The industries that require the services of a microbiological testing laboratory include
- Pharmaceutical and biotechnology industries for sterility and contaminant tests of their products.
- Food and beverage industries for pathogen detection, product shelf life, and product safety validation.
- Cosmetics and personal care industries for product safety and microbial safety of creams, lotions, and hygiene products.
- Water treatment industries for potable water safety and environmental discharge monitoring.
- Agriculture industries for microbiology of soils and crop diseases.
- Medical devices for bioburden and endotoxin tests.
- Environmental agencies for air, water, and surface contaminant monitoring.
The Fair Lab’s Microbiological Testing Laboratory is ready to serve all of the above industries with precision, speed, and scientific integrity.
Types of Microbiology Testing Services
Microbiology testing services is a vast field that covers numerous types of analytical tests and procedures. Understanding the types of microbiology testing services is the first step towards choosing the right service for your needs.
1. Microbial Contamination Testing
Microbial contamination testing is one of the most critical types of microbiology testing services. This type of test aims to detect and measure the presence of unwanted microorganisms in the product, raw materials, and manufacturing environment. This type of test is of utmost importance for the pharmaceutical, food, and cosmetic industries to ensure the safety of their products.
Common types of contamination tests include Total Aerobic Microbial Count (TAMC), Total Combined Yeast and Mold Count (TYMC), Salmonella, E. coli, Staphylococcus aureus, and Pseudomonas aeruginosa tests. Each of these contaminants poses unique health risks to consumers, and their detection is highly regulated.
2. Rapid Microbiology Testing
Traditional culture-based tests take days to deliver test results. However, the advent of rapid microbiology testing has completely revolutionized the field of microbiology. This type of test delivers test results significantly faster without compromising the accuracy of the test results. This type of test is highly beneficial for the manufacturing sector as well, as they can now make quick decisions about product release.
Popular types of rapid microbiology testing include:
- PCR (Polymerase Chain Reaction): Molecular-based detection of microorganisms in hours.
- ATP Bioluminescence: Real-time monitoring of surface and environmental contamination.
- Flow Cytometry: Fast cell counting and cell viability tests.
- MALDI-TOF Mass Spectrometry: Fast and precise identification of microorganisms.
- Immunoassay Methods: Fast antigen-antibody detection tests for specific microorganisms.
3. Environmental Microbiological Testing
Environmental monitoring is one of the most critical aspects of GMP compliance in the pharmaceutical and biotechnology industries. This type of test aims to detect the presence of microorganisms in the environment. This type of test includes air tests, surface tests, water tests, and personnel tests. This type of test is highly beneficial for the manufacturing sector as well, as it helps maintain the integrity of the product.
Importance of an ISO 17025 Microbiology Lab
When it comes to choosing the right lab for your critical testing needs, there are several factors to look into, with accreditation being one of the most significant considerations. An ISO 17025 microbiology lab is a lab that has proven its competence in delivering quality results to its clients.
What is ISO 17025? Accreditation?
ISO 17025 is the international standard that sets the criteria for the competence of testing and calibration laboratories. It is the general requirement for the competence, impartiality, and consistency of a testing laboratory. This is a third-party accreditation that proves the competence of the lab in delivering quality results to its clients.
Why Does ISO 17025 Accreditation Matter?
When it comes to choosing an ISO 17025 microbiology lab, there are several benefits that come with the choice:
- Global Acceptance — The lab’s test results are accepted by regulatory bodies, trading partners, and government agencies around the world.
- Increased Accuracy — Choosing an ISO 17025 Microbiology Lab ensures that the lab’s test results are free from errors.
- Regulatory Compliance — Choosing an ISO 17025 Microbiology Lab ensures that the client is in compliance with the regulatory requirements of the FDA, EMA, CDSCO, etc.
- Legal Defensibility — Choosing an ISO 17025 microbiology lab ensures that the client is legally defensible.
- Competitive Advantage — Choosing an ISO 17025 Microbiology Lab ensures that the client’s product is more marketable in the market.
The Fair Lab is an ISO 17025 microbiology lab that prides itself on delivering quality results to its clients.
GMP Microbiology Testing in Industries
Good Manufacturing Practice, or GMP, is a set of regulations that ensures the quality and consistency of products in the manufacturing industry. One of the most important and critical elements of the Good Manufacturing Practice system is the GMP Microbiology Testing.
Importance of GMP in Laboratories
GMP is the most important practice in the laboratory, as it ensures that the entire testing procedure is conducted in a manner that is free from errors, contamination, and false results. In the case of the GMP Microbiology Testing, the laboratory is meticulous in maintaining records, using equipment, and employing personnel.
GMP Microbiology Testing in the Pharmaceutical Industry
GMP microbiology testing is one of the most critical and essential testing procedures in the pharmaceutical industry, and it is mandated by the FDA, the European Medicines Agency, and the Central Drugs Standard Control Organisation in India. Some of the most important microbiology testing procedures in the pharmaceutical industry are sterility testing, microbial enumeration, testing for specified microorganisms, endotoxin testing, and bioburden testing.
If the regulations and procedures of the GMP Microbiology Testing are not followed, the consequences will be severe, and the company will face severe financial consequences and the shutting down of the manufacturing plant. Fair Lab’s services in the field of GMP microbiology Testing is the best in the industry, and the company is the most reliable in the field.
Microbial Identification Laboratory Process
The Microbial Identification Laboratory is a specialized laboratory focused on identifying the exact nature of the microorganisms isolated from the samples under investigation. Microbial identification is vital for contaminant identification, spoilage analysis, clinical diagnosis, and research purposes.
Culture-Based Identification Methods
The culture-based identification method is still the gold standard for microbial identification, and it is used for many applications. In the Microbial Identification Laboratory, the culture-based method is used for microbial identification, and the culture is plated on selective and differential media to obtain individual colonies of microorganisms. Biochemical tests, such as oxidase, catalase, indole, and citrate tests, are performed on the microorganisms to identify their metabolic characteristics and narrow down their identities.
Gram staining is the first step in microbial identification, and it categorizes bacteria as Gram-positive or Gram-negative based on the composition of their cell wall. Microorganisms are also identified by their morphology under a microscope, and their characteristics, such as shape, arrangement, and structure, are observed.
Molecular Microbiology Testing Methods
The Modern Microbial Identification Laboratories have adopted molecular microbiology, which is more accurate and quicker compared to other techniques. The molecular microbiology techniques include 16S rRNA gene sequencing for bacteria and ITS gene sequencing for fungi, providing accurate identification of microorganisms to the species level or even to the subspecies level for some microorganisms.
The game-changer in the field of microbial identification is MALDI-TOF mass spectrometry, as it is capable of identifying microorganisms to the species level based on the protein fingerprint of the microorganism. The Fair Lab offers accurate and comprehensive identification services by using both classical and molecular techniques in the Microbial Identification Laboratory.
Importance of a Microbiological Analysis Laboratory
A microbiological analysis laboratory involves a scientific study of a sample to identify, quantify, and characterize microorganisms. The importance of a microbiological analysis laboratory is vast, ranging from public health protection to manufacturing process regulations, as well as protection of the natural ecosystem.
Testing Procedures and Analysis of the Sample
The testing procedure used in a microbiological analysis laboratory is scientifically validated to ensure it is appropriate for the purpose. Some of the key stages in the analysis process carried out in a microbiological analysis laboratory include sample reception, sample integrity, homogenization, dilution preparation, plating, incubation, organism selection, biochemical and molecular analysis, result reporting, quantification of uncertainty, etc.
Each step in the entire process is subject to a Standard Operating Procedure, which is frequently revised in accordance with changes in regulations and advances in scientific knowledge. This ensures that the results obtained from a microbiological analysis laboratory are not only accurate but also legally defensible.
Food and Water Safety: Why It Matters
Food and water are two of the most critical things we monitor at our Microbiological Analysis Laboratories. Some of the big threats that we face in this regard are food-borne pathogens such as Salmonella, Listeria monocytogenes, Campylobacter, Shiga toxin-producing E. coli, etc. These pathogens can cause serious problems for public health. Then, of course, there are waterborne pathogens such as Cryptosporidium, Giardia, Legionella, etc., which can cause widespread problems if water is not kept under check.
We at Fair Lab provide comprehensive food and water testing services, which are compliant with FSSAI, BIS, WHO, etc. Our Microbiological Analysis Laboratory is fully equipped to provide these services.
Benefits of Rapid Microbiology Testing
Rapid microbiology testing is a revolutionary leap forward in modern science, and the technologies involved offer many advantages over conventional methodologies, providing industries with improved safety, efficiency, and productivity.
Speed as a core advantage
The first and foremost advantage of rapid microbiology testing is its speed. Conventional sterility tests using culture media take about 14 days of incubation as per pharmacopoeial guidelines, whereas rapid testing technologies offer results in a few hours and within one to three days, respectively.
Enhanced Product Safety
Rapid microbiology testing helps ensure product safety by detecting product contaminations early. If product contamination is detected before the product is shipped and consumed, the manufacturer may take prompt actions such as quarantining the product, investigating the cause of the problem, and remediating processes to prevent future occurrences, protect the company’s reputation, and, above all, ensure consumer safety.
Cutting-Edge Rapid Microbiology Testing Technologies
The science of rapid microbiology testing is dynamic and continuously evolving, with new technologies and techniques being developed regularly. Next-generation sequencing (NGS) allows for the full characterization of the microbial communities in a single run, giving us deeper insights into the results of the test. Digital PCR, on the other hand, enables us to quantify the number of microorganisms of concern with absolute precision, without the need for standard curves. Microfluidics is a technology that miniaturizes complex analytical processes into small, portable devices for use at the point of need, such as in the factory, in the field, or in the clinic.
The Fair Lab is committed to investing in the latest rapid microbiology testing technologies to provide our clients with the fastest, most accurate, and most cost-effective solutions available today.
Why Choose The Fair Lab for Microbiology Testing Services?
There are several labs that compete to conduct your microbiology tests, but it is always wise to select the best lab to conduct your microbiology tests. The Fair Lab is the best lab to conduct your microbiology tests with the help of its unique combination of scientific competence, quality systems accredited to standards, state-of-the-art technology, and commitment to your success.
- ISO 17025 Accreditation: Our lab is accredited with the ISO 17025 standard, which ensures that the quality of our microbiology testing services is of the highest level.
- GMP Compliant Operations: All our operations are GMP compliant, which is a guarantee of compliance with regulatory requirements for our pharmaceutical and food industry clients.
- Comprehensive Service Portfolio: Our Microbiology Testing Services are designed to meet the needs of our clients with our comprehensive service portfolio, which covers the entire gamut of microbiology tests.
- Rapid Turnaround Times: We offer our clients the flexibility to select the turnaround time that suits their requirements with our standard, priority, or express turnaround times.
- Expert Scientific Team: Our Microbiology Testing Services are conducted in our lab by highly qualified microbiologists with considerable experience in the pharmaceutical, food, cosmetics, and environmental sectors.
- Competitive Pricing: Our Microbiology Testing Services are provided to our clients at the most competitive price with no hidden costs, thus making our services affordable to businesses of all sizes.
- Client-Centric Approach: Our Microbiology Testing Services are designed to collaborate with our clients with the help of our client-centric approach.
Conclusion: Partner with Professional Microbiology Testing Labs
When it comes to microbiology testing, it is not merely about complying with regulations; it is an actual investment in safety, quality, and trust from the consumers. As the nature of the supply chain becomes increasingly complex and regulations continue to shift, the need to partner with a reputable and professional microbiology testing lab becomes stronger and stronger.
Do you need microbial limits, precise molecular identification, fast contamination tests, or detailed environmental monitoring? The Fair Lab’s Microbiology Testing Labs are prepared to provide the results you need. With our ISO 17025 accreditation and GMP compliance, combined with our experienced microbiologists, we guarantee that each client receives the best analytical services that meet their unique needs.
Becoming a client of The Fair Lab means more than just receiving the services of a reputable microbiology testing lab; it is a partnership with a scientific ally that is committed to helping you achieve the highest safety and quality standards possible. Let us discuss our wide range of microbiology testing services and see how we can assist you in your quality assurance journey.
Frequently Asked Questions (FAQs)
Q1. What are the microbiology testing services?
Microbiology testing services are specialized services offered in the laboratory for the detection, identification, and quantification of microorganisms, which include bacteria, fungi, viruses, and parasites in various types of samples. These samples include pharmaceuticals, food and beverages, water, swabs from the environment, and raw materials. This is done to ensure safety and compliance with regulatory requirements for the protection of the public.
Q2. Why is the Microbiological Testing Laboratory important for the pharmaceutical industry?
The microbiological testing laboratory is of prime importance for the pharmaceutical industry because the drug product should be free from pathogenic microorganisms to ensure safety for the end user. The regulatory agencies, such as the FDA, EMA, and CDSCO, require the product to undergo the test for the detection of microorganisms during the raw material stage, in-process stage, finished product stage, and stability stage. Failure to comply with the regulations could be dangerous for the end users.
Q3. What is ISO 17025 accreditation, and why is it important?
ISO/IEC 17025 is the international standard that defines what a testing and calibration lab must demonstrate in terms of technical competence. If the Microbiology Lab is accredited to the standard, an evaluation of the lab’s results ensures that they are technically valid and reproducible. Such accreditation is respected worldwide, including by regulators, global enterprises, and government agencies, due to the assurance that the results provided by the lab are reliable and scientifically valid.
Q4. What is rapid microbiology testing, and which industries reap the maximum benefits?
Rapid microbiology testing refers to the application of cutting-edge technology that significantly reduces the time taken for the detection and identification of microorganisms, unlike the traditional culture-based methods. For instance, the use of tools like PCR, MALDI-TOF, ATP bioluminescence, and flow cytometry is employed for the purpose. Industries that reap the maximum benefits of rapid microbiology testing include the pharmaceutical, food, beverage, medical device, and environmental sectors.
Q5. What is GMP microbiology testing?
GMP microbiology testing refers to the practice of conducting microbiology testing in an environment that adheres to the rules of Good Manufacturing Practice. GMP microbiology testing is compulsory for the pharmaceutical, medical device, food, and cosmetics industries. GMP ensures that the microbiology testing process is standardized, written, and developed in such a manner that errors, contamination, and integrity issues are avoided.
Q6. What methods does a microbial identification laboratory use?
The Microbial Identification Lab is a mix of old and new approaches to identify microorganisms accurately. The old approaches include Gram staining, biochemical tests, and growth on selective media. The new approaches include 16S rRNA gene sequencing, MALDI-TOF mass spectroscopy, whole-genome sequencing, and PCR-based tests. The approaches depend on the type of microorganism, the precision needed (genus, species, or strain), and the need for immediate results.
Q7. How does a microbiological analysis laboratory ensure the accuracy of results?
The Microbiological Analysis Lab is committed to ensuring the accuracy of results through various means, including the validation of test procedures, regular calibration and maintenance of equipment, the use of certified reference materials and quality control cultures, participation in proficiency tests, personnel training and competency verification, and a quality management system. At The Fair Lab, this is done through the incorporation of the aforementioned procedures in the day-to-day activities of the lab to ensure the precision and dependability of results.
Q8. What types of samples can be tested at microbiology testing labs?
The Microbiology Testing Labs test various types of samples, ranging from pharmaceutical products (tablets, liquids, injectables) to raw materials and excipients, food and beverages, drinking water and wastewater, environmental swabs and air samples, cosmetics and personal care products, medical devices and their packaging, soil and agricultural products, and clinical samples. The Fair Lab is able to handle all the aforementioned sample types appropriately and safely.
Q9. How long does microbiological testing typically take?
The length of time for microbiological tests varies based on the type of test and method of testing. Microbial counts take three to five business days for routine culture tests, whereas pathogen detection may take five to seven days using conventional techniques or as little as one to two days using molecular techniques. Sterility tests, as per pharmacopoeial procedures, take at least 14 days to conduct.
Rapid microbiology techniques may take as little as a few hours or as many as two days, depending on the method of detection.
Q10. How do I submit samples to The Fair Lab for microbiology testing services?
It is quite easy to submit your samples for testing with The Fair Lab for Microbiology Testing Services. First, you may contact us either through our website or over the phone to initiate your sample testing request. We will then send you a sample submission form, sample collection instructions, and information on how to properly submit your sample for testing. After your sample is received, it will be entered into our Laboratory Information Management System (LIMS) and assigned to the appropriate testing team for evaluation and reporting of results, which will be transmitted electronically in a certified test report format.